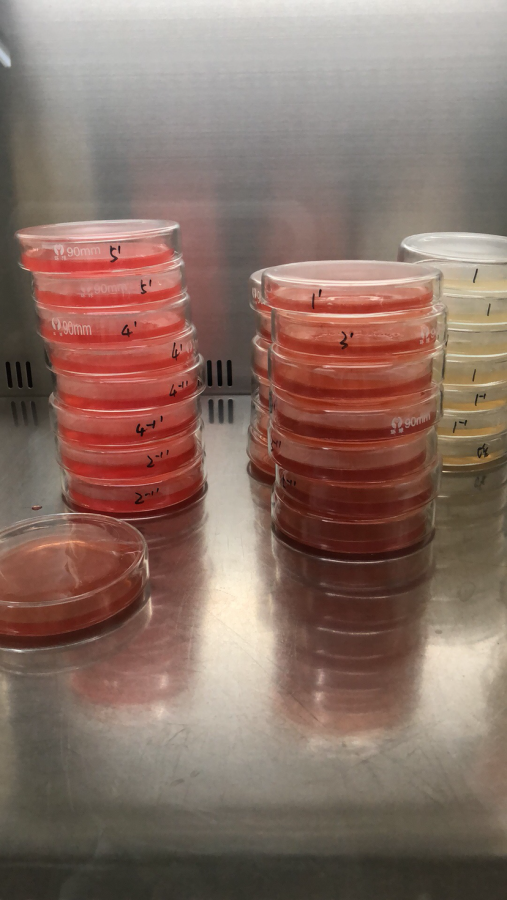
虎红培养基颜色不同是为何

培养 颜色

左图为与空气接触时间过长,ph升高后颜色;右图为正常培养基颜色
图片尺寸1269x659
生物实验现象 配的培养基颜色怎么不对啊?
图片尺寸500x374
虎红培养基颜色不同是为何
图片尺寸507x900
沙门氏菌显色培养基1_7075.jpg
图片尺寸358x269
试管和绿叶在皮氏培养皿,颜色背景上进行测试
图片尺寸700x573
颜色液体在旧塑料培养皿
图片尺寸700x467
在培养皿上蓝色背景颜色液体
图片尺寸700x467
蒙氏教具木制儿童早教叠彩虹套圈培养颜色认知协调配对套柱玩具
图片尺寸800x800
大家看看国产的显色培养基上面的沙门氏菌
图片尺寸660x652
用滴颜色液体和培养皿吸管
图片尺寸700x1003
在培养皿上蓝色背景颜色液体
图片尺寸700x467
试管和绿叶在皮氏培养皿颜色背景上进行测试
图片尺寸700x493
生物专家用培养皿画画画成的细菌作品色彩炸裂
图片尺寸650x650
在培养皿上灰色背景颜色液体
图片尺寸700x467
生物专家用培养皿画画画成的细菌作品色彩炸裂
图片尺寸660x660
生物专家用培养皿画画画成的细菌作品色彩炸裂
图片尺寸640x640
生物专家用培养皿画画画成的细菌作品色彩炸裂
图片尺寸660x660
调色实验:通过观察与比较进行颜色对应,并培养视觉记忆力和思维记忆力
图片尺寸2667x2000
生物专家用培养皿画画,画成的细菌作品,色彩炸裂
图片尺寸1000x1000
大肠菌群显色培养基
图片尺寸640x479